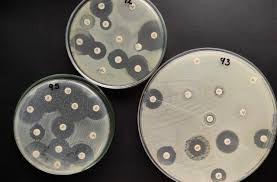

Práctica 9: Antibiograma
15/01/25
INTRODUCCIÓN:
El antibiograma consiste en un método in vitro que determina la susceptibilidad de los microorganismos a una variedad de agentes antimicrobianos, en unas condiciones de laboratorio específicas y estandarizadas.
Para los antibióticos se utiliza el Método de Difusión en Disco (Baeur-Kirby), y el medio de cultivo que se usa es el Mueller Hinton.
Los resultados ayudan en la prescripción del tratamiento más efectivo, y a controlar las infecciones nosocomiales, que se adquieren en hospitales. Monitorear la resistencia a los antibióticos es crucial para la salud pública.

OBJETIVOS:
- Realizar el antibiograma.
- Recordar como se realiza la técnica por inundación.
- Identificar los antibióticos ante los cuales las bacterias son sensibles, intermedios o resistentes.
MATERIALES:
- 5 tubos.
- Gradilla.
- Medio de cultivo Mueller-Hinton.
- Staphylococcus epidermidis (en un medio de cultivo líquido).
- Pipeta de vidrio de 5 ml.
- Micropipeta de 100-1000 μl.
- Puntas azules.
- Rotulador permanente.
- Asa de siembra desechable.
- Antibioticos: Estreptomicina, Ciprofloxacin y Ampicilina.
- Estufa.
- Campana extractora (Botón FAN - luz ultravioleta (10-15 min) - luz de trabajo).
PROCEDIMIENTO:
1. En una gradilla se tienen cinco tubos de base cónica numerados del 1 al 5, en los cuales se van a hacer una serie de diluciones.
2. En los cinco tubos se depositan 4,5 ml de agua destilada (con una pipeta de vidrio de 5 ml) y se lleva la gradilla a la campana.
3. Se coge una micropipeta de 100-1000 μl para coger 500 μl del medio líquido en el que se encuentra la bacteria.
4. Después de coger los 500 μl del medio líquido, se echan en el tubo 1, se homogeniza y se desecha la punta azul en el contenedor amarillo (para homogeneizar se pone el dedo encima y se agita).
5. Se coge otra punta azul, y se traspasan 500 μl del tubo 1 al tubo 2, y se repite el procedimiento.
6. Se hace lo mismo con el resto de tubos.
7. Se coge una placa con Mueller Hinton, que se marca con el nombre del grupo.
8. El tubo 5 se vierte entero en la placa correspondiente y se gira la placa unas 5-6 veces en sentido horario, y 5-6 veces en sentido contrario.
9. Se colocan dos discos con ayuda de dos asas de siembra desechables.
10. Se lleva la placa a la estufa a 37ºC durante 24 horas.
Ahora se añade un vídeo realizado por este grupo de la práctica.
RESULTADOS:
INTERPRETACIÓN DE LOS RESULTADOS:
Como no ha crecido nada en la placa, no se pueden medir los halos de inhibición para ver si las bacterias eran sensibles o resistentes para los dos antibióticos, así que se añade una imagen de un buen resultado.